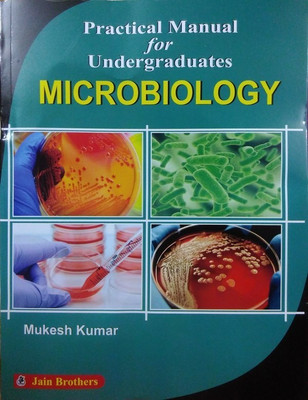

Practical Manual for Undergraduates Microbiology(English, Paperback, Mukesh Kumar)
Quick Overview
Product Price Comparison
CONTENTS :- 1. Precautions in Microbiology Laboratory 2. Compound Microscope 3. Fluorescent Microscope 4. Stains in Microbiology 5. Gram's Staining 6. Ziehi-Neelsen of Staining 7. Albert's Method of Staining 8. Spore Staining 9. Capsule Staining 10. Sterilisation and Disinfection 11. Hanging Drop Preparation 12. A. Culture Media, B. Solid Media 13. Liquid Culture Media 14. Biochemical Reaction-1 (Catalase, Oxidase, Sugar Fermentation, Indole, H2S Production, MR, VP) 15. Biochemical Reaction-2 (Urease test, Citrate Utilisation Test, PPA,of Test, Nitrate Reduction Test, Decarboxylase Test) 16. Diagnostic Microbiology (Sample Collection, Transport and Processing) 17. Diagnostic Microbiology 18. Serology(VDRL and RPR) 19. Serology (CRP,ASO,RF) 20. Serology(Widal Test, Weil-Felix Test, SAT) 21. Serology (ELISA, ICT, IFA) 22. Antimicrobial Sensitivity Tests (Disc Diffusion Method) 23. Antimiocrobial Sensitivity Test (MIC Test) 24. Staphylococcus Aureus 25. Coagulase Negative Staphylococcus 26. Methicillin Resistant Staphylococcus Aureus 27. Streptococcus Pyogenes, Streptococcus Agalactiae 28. Enterococcus sp. 29. Vancomycin Resistant Enterococcus 30. Corynebacterium Diphtherae 31. Bacillus 32. Anaerobic Culture Methods 33. E. coli 34. Klebsiella 35. Proteus 36. ESBL 37. Salmomella 38. Shigella 39. V. Cholerae 40. Pseudomonas 41. Mycobacterium Tuberculosis 42. Mycobacterium Leprae 43. Diagnostic Approach in Virology 44. Diagnostic Approach in Parasitology 45. Entamoeba Histolytica 46. Giardia Lamblia 47. Plasmodium Falciparum 48. Plasmodium Vivax 49. Leishmania 50. Taenia 51. Echinococcus 52. Hymenolepis Nana 53. Trematodes 54. Hookworm 55. Roundworm 56. Strongyloides 57. Trichuris Trichiura 58. Microfilaria 59. Medical Entomology 60. Diagnostic Approach in Mycology 61. Morphology of Fungi 62. Candida 63. Cryptococcus 64. Aspergillus 65. Dermatophytes 66. Zygomycetes (Rhizopus, Mucor) 67. Tutorials Syndromic Approach 68. Colour Plates.